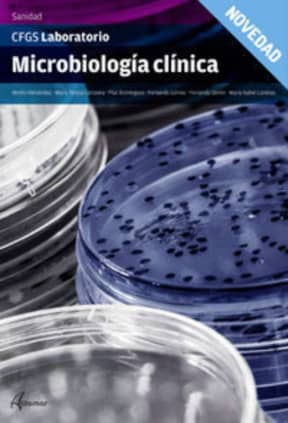
MICROBIOLOGIA CLINICA. ALTAMAR 16

Fisiopatología general
35,10 €
36,95 €
-5%

GESTION DE MUESTRAS BIOLOGICAS
33,21 €
34,95 €
-5%

Dispensación de productos farmacéuticos
30,40 €
32,00 €
-5%